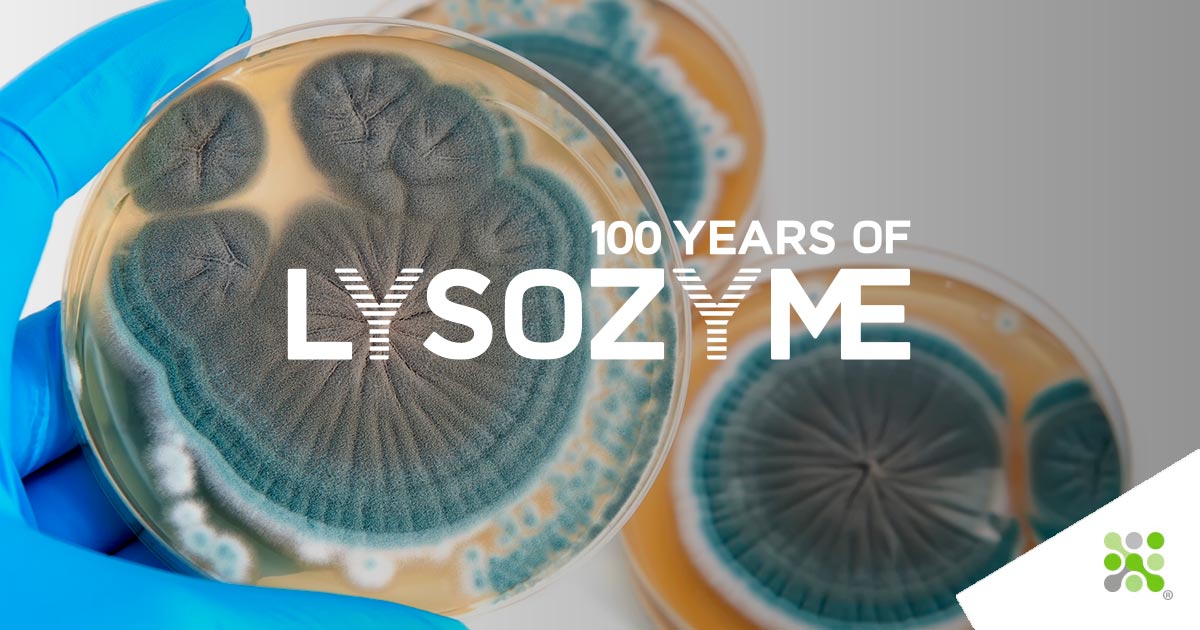

bioseutica®
The 1st choice for food, pharma, and feed ingredients
Discover Bioseutica®: Innovators in Natural Proteins and Enzymes for Food, Pharma, and Feed Industries
We are a leading ingredients company, and our natural proteins and enzymes are the first choice across the food, pharma, and feed industries. With a tradition of innovation spanning nearly 75 years as an enzyme manufacturing company, we aim to become the global market leader in the responsible development of proteins with our proprietary solvent-free processes. We are committed to R&D, knowing that scientific developments have led to the definition of our innovative portfolio of products, patents, and proprietary technologies. At Bioseutica®, we focus on the global supply of non-GMO ultrapure bioactive proteins and functional foods, extracting nature’s best from eggs and the pancreas. Our egg-derived proteins are highly valued across broad industries that take inspiration from their roles in nature. Lysozyme, Avidin, and Ovotransferrin (conalbumin) possess potent natural antimicrobial properties, utilized extensively across food processing, food safety, animal health, nutrition, hygiene, and pharmaceutical industries. Bioseutica® is a globally recognized enzyme company for food, nutrition, health supplements, animal healthcare, and pharmaceuticals. Leveraging our expertise as global leaders in Lysozyme production, we have developed specialty formulations, including the natural nootropic NA2R®, LYSOVIN™ for precision fermentation in winemaking, LYSOLAC® for dairy products, and the livestock immunity-boosting Entegard® range.
Bioseutica® Group
Bioseutica® Group comprises Neova Technologies Inc., Fordras SA, and Healiva SA. Neova Technologies Inc., based in Abbotsford, Canada, draws on forty years of expertise in bioseparation and protein fractionation, having built its reputation on quality and customer service. Fordras SA, based in Lugano, Switzerland, has served the pharmaceutical and food industries since 1983. Healiva SA, also based in Lugano, Switzerland, was launched in 2020. An innovative patient-centric biotech company that delivers affordable precision therapeutics to improve people's quality of life. Using a multi-pronged approach, Healiva SA combines digital health, enzyme technology, and cell therapy to address unmet patient needs in regenerative wound care.
Neova Technologies Fordras Healiva
Beyond the Egg: High-Quality Pancreatic Digestive Enzymes
Beyond the egg, we also extract pancreatic digestive enzymes, including Trypsin, chymotrypsin (protease), Aquatryp® (A non-mammalian, non-microbial enzyme mixture), and Phospholipase A2 (hydrolase). These protease and protease blends have extensive applications in food, nutrition (infant and follow-on formulae), diagnostics, dietary supplements, food processing, pharmaceutical, and medical research applications requiring the faithful mimicking of natural digestive processes. Our manufacturing processes are built on these high-end, cutting-edge proprietary technologies, allowing us to produce ingredients of the highest quality in our facilities across Canada and Europe. Our international reputation is built on our quality and service reliability.
Explore Bioseutica® High‑Purity Reagents

Ultrapure egg-derived proteins for diagnostics, pharma, and functional nutrition
Extracting nature’s best from eggs to deliver ultrapure bioactive proteins and innovative reagents for diagnostics, pharma, and functional nutrition worldwide. Bioseutica® supplies high-purity egg-derived proteins such as lysozyme, avidin, ovalbumin, and ovotransferrin, trusted across research, diagnostic, and industrial applications for their natural functional and antimicrobial properties.
As an integrated manufacturer, we provide consistent quality, full traceability, and flexible supply options for your laboratory workflows, product development pipelines, and regulated production environments.Request a customized quotation for AVIDIN, AFFIAVIDIN, LYSOZYME HCl, LYSOHT®, OVALBUMIN, OVOTRANSFERRIN, AMCIPATRICIN, and AMCIPATRICIN Diascorbate tailored to your project’s specifications. Our team will respond with pricing, lead times, and technical documentation to support your application.
Leading Enzyme Manufacturer for the USA and China markets: Excellence in Muramidase, Hydrolase, and Protease Solutions
As a premier enzyme manufacturer for the USA and China markets, Bioseutica® stands at the forefront of biotechnological innovation, delivering high-quality muramidase, hydrolase, and protease solutions to global customers. Our cutting-edge facilities and commitment to excellence ensure that each product we manufacture meets stringent quality standards, making us a trusted partner in the enzyme industry. With a robust focus on sustainability and efficiency, our enzymatic solutions cater to various applications, helping industries enhance performance and achieve their environmental goals. Whether in the USA, China, or any other part of the world, rely on Bioseutica® for superior enzyme manufacturing services tailored to your needs.
About us Our Products Read our Blog
Bioseutica® goes circular! Opportunities for West III program grant

Bioseutica® is leading a project to develop a novel lysozyme product (bioactive protein) for the feed industry through the extraction of lysozyme from a residual feed stream. This Technical Lysozyme will be produced within a circular stream of valuable protein sources for the feed industry. The initiative receives financial support from the European Union through the EFRO program Opportunities for West III. This program focuses on the transition to a fully circular and climate-neutral economy, with an important milestone at the end of the program period in 2030.
Pipeline
Bioseutica® is in the advanced R&D development of amcipatricin by inhalation to treat and prevent severe fungal infections in cystic fibrosis or immunocompromised patients (patent pending). Bioseutica® is looking for development and commercial partners.

Fungal diseases are a public health issue: opportunistic infections (e.g., cryptococcosis and aspergillosis), hospital-associated infections (e.g., candidemia), and community-acquired infections pose a critical threat to public health1. Globally, over 300 million people are afflicted with a severe fungal infection, and 25 million are at high risk of dying or losing their sight2. AMCIPATRICIN diascorbate (code SPK-843) is a new semi-synthetic, water-soluble polyene antibiotic with potent broad-spectrum antifungal activity, particularly against Candida spp., Cryptococcus sp., and Aspergillus spp.
100 years of Lysozyme
2022 marked 100 years since news of Lysozyme’s discovery reached the Royal Society. Let us take you on the journey of this 100-year story:
Media
About Bioseutica®
Discover Bioseutica® a leading ingredients company whose natural proteins and enzymes are the first choice across food, pharma, and feed industries. With a tradition of innovation spanning nearly 75 years, we aim to become the global [...]
Bioseutica® Food Ingredients
An overview of our natural food ingredients for clean-label products. Bioseutica®'s enzymes and proteins are solvent and GMO-free to ensure the highest quality standard[...]
Bioseutica® NA2R®
NA2R® is a clinically proven natural ingredient for the novel food/nootropics industry. Its daily consumption leads to increased brain serotonin levels, exerting physiologically beneficial effects on the brain[...]
Membership
Bioseutica® is a DCAT, The Drug, Chemical & Associated Technologies Association member, which powers relationships and industry knowledge for pharmaceutical development and manufacturing companies. DCAT is a 501(c)6, not-for-profit, member-supported, global business development association whose unique membership model integrates innovator and generic drug manufacturers and suppliers of ingredients, development and manufacturing services, and related technologies. Since 1890, DCAT has provided a life-long collegial community for industry representatives for over 125 years. DCAT is committed to providing programs, events, and services that help members meet their business objectives, expand their network of customers and suppliers, and gain insight into industry trends, markets, and issues impacting pharmaceutical development and manufacturing.
Compliance
Each of Bioseutica®'s affiliates holds certifications attesting to our commitment to the highest possible quality standards.
- HACCP certification for our plants in North America
- Lysozyme Kosher certification
- Lysozyme Halal certification
- GMP certificates for Lysozyme plants in the EU
- Lysozyme is affirmed as GRAS by the US Fed. Register of rules and regulations since 1998
- GDP by Swissmedic
- FSSC 22000
TRYPSIN is highly valued as a workhorse protease across a range of industries due to its potent digestion of proteins.
Lysozyme, one of the most powerful natural antibacterial and antiviral compounds known to man, has been used in foods and pharmaceuticals for over three decades as it naturally inhibits the growth of many spoilage organisms, increases a healthy shelf life and ensures food safety. It also boosts the immunity system.
AVIDIN is a glycoprotein extracted from egg white using ion-exchange or affinity chromatography. Its biological importance was discovered in 1926 when rats were fed egg white and developed dermatitis, loss of hair and disruption of muscular co-ordination.
OVOTRANSFERRIN also called Conalbumin, is a glycoprotein with a molecular weight of 76,000. OVOTRANSFERRIN comprises approximately 13% of the protein content of egg albumen. More than sixty years ago, researchers determined
NA2R® is a clinically proven natural ingredient for the novel food/nootropics industry. Its daily consumption leads to increased brain serotonin levels, exerting physiologically beneficial effects on brain functions like the mood that, in turn, could promote the feeling of well-being, particularly during stressful times, as well as help emotional and cognitive functions.
AQUATRYP™ is our ready-to-use gentle enzymatic cell detachment reagent. A non-mammalian, non-microbial enzyme mixture, AQUATRYP™ can be readily incorporated into most routine cell culture protocols.
OVALBUMIN one of the most extensively characterised and best-understood antigens, contributing to our understanding of the structure-function relationship of antigen-antibody interactions.
Latest news
EFSA : Lysozyme does not give rise to safety concerns
The food enzyme lysozyme (peptidoglycanN-acetylmuramoylhydrolase; EC 3.2.1.17) is produced from hens eggs by Bioseutica® B.V. It is intended to be used in brewing processes, milk processing for cheese production as well as wine production. The dietary exposure to the food enzyme–total organic solids (TOS) was estimated to be up to 4.9 mg TOS/kg body weight per day.
Enhancing Protein Product Quality: Ovotransferrin as a Superior Substitute for Lactoferrin
To improve your protein products' processing quality and biological activities? Try using Ovotransferrin as a lactoferrin substitute. Ovotransferrin (OVT) is a protein that has a high similarity to Bovine lactoferrin (BLF) and human lactoferrin (HLF) and may be used as a substitute for lactoferrin (LF) due to its limited production.